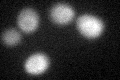

View description
Protein of unknown function, member of the seripauperin multigene family encoded mainly in subtelomeric regions; identical to Pau6p
Localization:
Intensity:
Fold change:
Significance:
-
C’ GFP library in SD

below threshold16.13 -
N' NOP1pr-GFP in SD

N/A0 -
N' TEF2pr-mCherry in SD

N/A0 -
N' NATIVEpr-GFP in SD

N/A0 -
N' TEF2pr-VC and Cyto-VN in SD

N/A0 -
C’ GFP library in SD+DTT
cytosol17.421.07No -
C’ GFP library in SD+H2O2

cytosol16.681.03No -
C’ GFP library in Starvation Media

cytosol15.510.96No -
C’ GFP library on the background of Pup2-DaMP

N/A -
C’ GFP library on the background of CCT mutant

N/A0N/AYes
